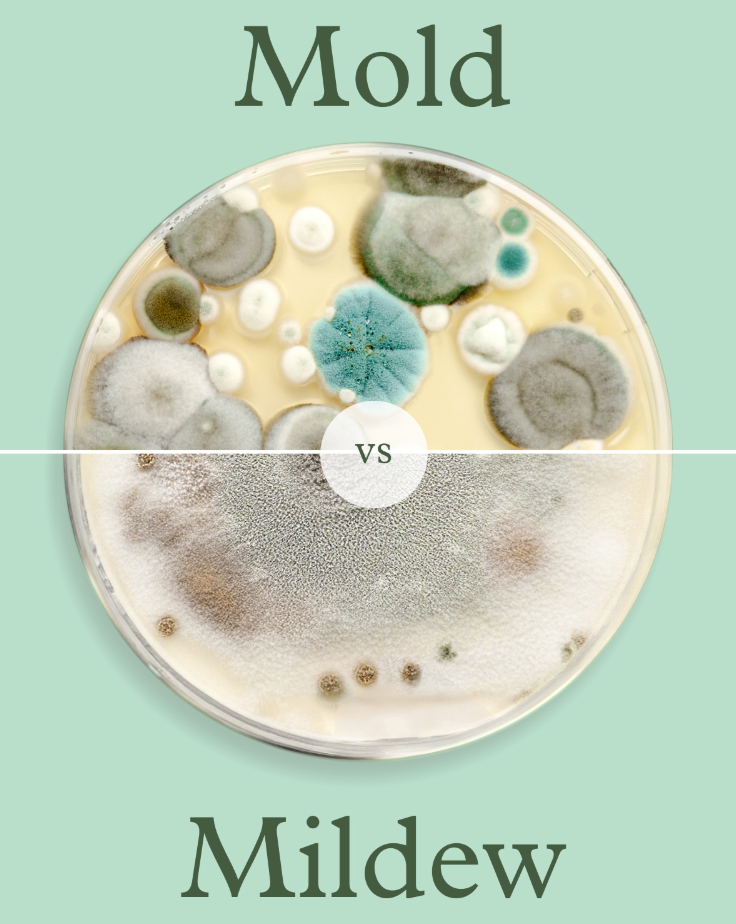
Mold<sup style="font-size: 65%;"> 1</sup> vs Mildew<sup style="font-size: 65%;"> 1</sup>. What's the difference?

Mold 1 vs Mildew 1. What's the difference?
Understand how to spot, prevent, and tackle mold 1 and mildew 1 for a healthier home
When it comes to indoor air quality and home maintenance, the terms mold 1 and mildew 1 are often used interchangeably—but they are not the same. Understanding the difference can help you better protect your home and health.
Mold 1 vs. Mildew 1: Key Differences.
Mildew is a type of surface fungus 1 that typically appears as a gray or white powdery substance. It grows on damp surfaces, such as bathroom tiles, shower curtains, or windowsills. Mildew 1 is often easier to clean and less harmful compared to mold 1, but it still thrives in moisture and humidity, signaling potential trouble areas.
Mold 1, on the other hand, is a more serious problem. It’s a fungus 1 that can penetrate deep into porous surfaces, including wood, drywall, and carpets. Mold appears in various colors, such as black, green, or brown, and often has a fuzzy or slimy texture. Mold 1 growth can cause structural damage to your home and trigger allergies or respiratory issues.
While mildew 1 is often limited to cosmetic damage, mold has the potential to cause significant harm, both to your home and your well-being.
Common Places Mold 1 and Mildew 1 Grow in the Home.
Mold 1 and mildew 1 thrive in areas with high moisture and poor ventilation. Some of the most common areas in your home include:
- Bathrooms: With constant exposure to water and humidity, bathrooms are prime spots for both mold 1 and mildew 1. Look out for growth around the edges of your shower, sink, or toilet.
- Basements: Basements are prone to dampness, especially in homes with poor drainage or water damage. This makes them an ideal breeding ground for mold 1.
- Kitchens: Leaky pipes or under-sink areas often harbor mold 1 and mildew 1, as do refrigerators and dishwashers.
- Windows and Attics: Condensation and roof leaks can lead to mold 1 and mildew 1 in these less-visible areas.
How Puraclenz Can Help.
Puraclenz CORE and Photon purifiers are specifically engineered to combat mold 1 at its source. Unlike conventional air purifiers, Puraclenz’s technology actively cleans the air and surfaces in your home 24/7. Mold 1 doesn’t stand a chance against our advanced purification system, which breaks down mold 1 spores before they can grow and spread.
When it comes to fighting mold 1, Puraclenz is truly Mold’s 1 #1 Enemy—keeping your home clean, fresh, and free from harmful contaminants. Choose Puraclenz and breathe easier knowing your home is protected.
Recommended products
Core Air & Surface Purifier + HEPA
$649.99
Photon Air & Surface Purifier
$399.99



